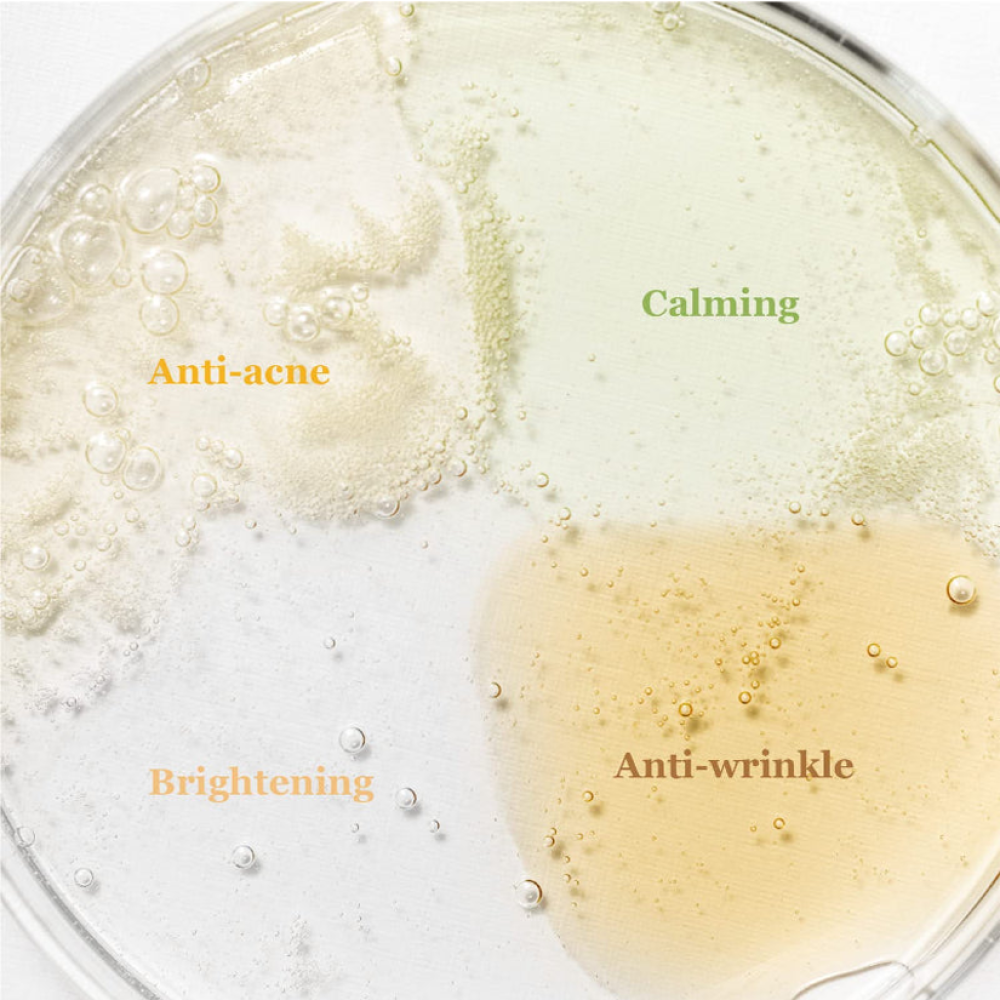

%100 original
Click here for more from the brand Beauty of Joseon
Beauty of Joseon Hanbang Serum Discovery Kit – 10 × 4ml
وفر 30.03
68.94
98.97 SAR- Available
Certified Warranty
We guarantee 100% original product quality.
Competitive pricing
The best offers and prices only at Cosmetics
Fast delivery
Fast delivery to all cities in the Kingdom
Beauty of Joseon Hanbang Serum Discovery Kit – 10 × 4ml includes a selection of the brand’s most popular serums inspired by traditional Korean Hanbang ingredients. The set offers hydration, soothing, brightening, and anti-aging benefits in travel-friendly sizes. Perfect for trying different formulas before committing to full-sized products. Suitable for all skin types, including sensitive skin.
Benefits:
- Variety of serums to target multiple skin concerns.
- Enriched with traditional Korean Hanbang ingredients.
- Provides hydration, soothing, brightening, and anti-aging care.
- Travel-friendly size, ideal for testing or on-the-go use.
- Suitable for all skin types, including sensitive skin.
How to use:
After cleansing and drying your face, apply a suitable amount of the chosen serum (4ml) to your face and neck. Gently massage until fully absorbed. Alternate serums or use according to your skin’s needs.
Order now from Cosmetics
Products you may like
Products I've viewed recently
Products previously viewed

Comments